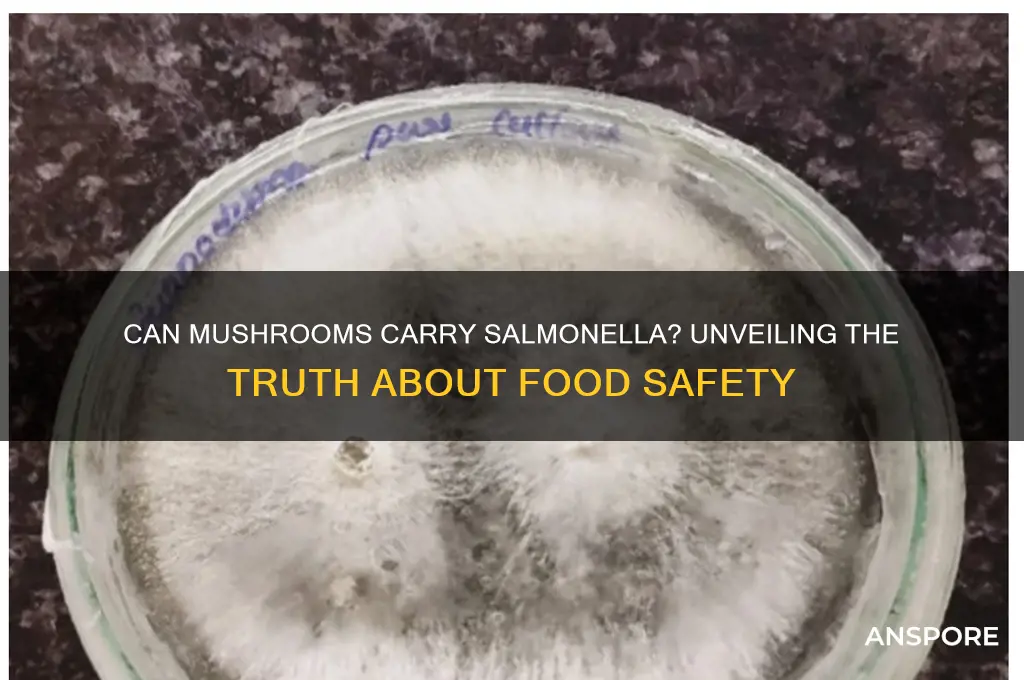
can mushrooms carry salmonella

Mushrooms, while generally considered safe and nutritious, have raised concerns about their potential to carry harmful bacteria such as Salmonella. Unlike produce grown in soil, mushrooms are cultivated in controlled environments, which reduces their exposure to common sources of contamination. However, Salmonella can still be introduced through contaminated growing substrates, water, or handling practices during harvesting and processing. While cases of Salmonella linked to mushrooms are rare, they are not unheard of, prompting food safety experts to emphasize proper handling, cooking, and storage to minimize risks. Understanding the potential for contamination and adopting preventive measures can help ensure that mushrooms remain a safe and healthy addition to diets.
| Characteristics | Values |
|---|---|
| Can mushrooms carry Salmonella? | Yes, but rare |
| Primary Source of Contamination | Cross-contamination during handling, processing, or storage |
| Common Contamination Points | Soil, water, or surfaces during cultivation or packaging |
| Risk Factors | Improper hygiene, unsanitary conditions, or contact with contaminated materials |
| Symptoms of Salmonella Infection | Diarrhea, fever, abdominal cramps, and vomiting (typically within 6-72 hours of consumption) |
| Prevention Measures | Proper washing, thorough cooking, and maintaining clean handling practices |
| FDA/USDA Guidelines | Recommend cooking mushrooms thoroughly to reduce risk |
| Reported Cases | Extremely rare; most cases linked to cross-contamination, not inherent mushroom contamination |
| Shelf Life Impact | Improper storage can increase risk of bacterial growth, including Salmonella |
| Organic vs. Conventional | No significant difference in Salmonella risk; contamination depends on handling practices |
Explore related products
What You'll Learn

Mushroom growing conditions and salmonella risk
Mushrooms, unlike animals, do not naturally harbor Salmonella. However, their growing conditions can introduce this pathogen, turning a healthy food into a potential health hazard. The risk lies in the substrate—the material mushrooms grow on, often composted manure. If this manure is contaminated with Salmonella, the bacteria can survive the composting process and transfer to the mushrooms. This is particularly concerning for button mushrooms (*Agaricus bisporus*), which are commonly grown on manure-based substrates.
To minimize Salmonella risk, mushroom growers must adhere to strict sanitation protocols. The composting process should reach temperatures of 140-160°F (60-71°C) for several days to kill pathogens. After composting, the substrate should be pasteurized at 122°F (50°C) for at least 6 hours. Growers should also implement biosecurity measures, such as using clean water, disinfecting equipment, and restricting access to growing areas. For home growers, sourcing certified Salmonella-free substrate and avoiding raw manure are critical steps.
Comparatively, wild mushrooms are less likely to carry Salmonella unless they grow in contaminated environments, such as near animal waste. However, the risk is not zero, especially in urban or agricultural areas. Foragers should avoid picking mushrooms near livestock or wildlife habitats and always cook them thoroughly, as heat (165°F/74°C) effectively kills Salmonella. This contrasts with commercially grown mushrooms, where controlled environments reduce but do not eliminate risk.
The takeaway is clear: Salmonella contamination in mushrooms is preventable with proper growing practices. For consumers, purchasing mushrooms from reputable sources and cooking them adequately are simple yet effective safeguards. While mushrooms themselves are not natural carriers, their growing conditions demand vigilance to ensure they remain a safe and nutritious food choice.
Magic Mushrooms and Drug Tests: Will Psilocybin Cause a Fail?
You may want to see also

Salmonella contamination in wild vs. cultivated mushrooms
Mushrooms, whether wild or cultivated, are generally considered safe to eat, but their susceptibility to Salmonella contamination varies significantly based on their environment and handling. Wild mushrooms, for instance, grow in natural settings where they can come into contact with animal feces, a primary source of Salmonella. This risk is particularly high in areas frequented by wildlife or domestic animals, as their droppings can introduce the bacteria into the soil. Cultivated mushrooms, on the other hand, are grown in controlled environments, often on sterilized substrates like compost or straw, which reduces the likelihood of Salmonella contamination. However, if proper hygiene practices are not followed during harvesting, packaging, or storage, even cultivated mushrooms can become contaminated.
To minimize the risk of Salmonella in wild mushrooms, foragers should adhere to specific guidelines. Always collect mushrooms from areas away from animal habitats or agricultural fields where manure might be present. After harvesting, thoroughly clean the mushrooms by brushing off dirt and rinsing them in cold water. Cooking wild mushrooms at temperatures above 160°F (71°C) for at least 15 minutes can effectively kill Salmonella and other pathogens. For cultivated mushrooms, consumers should look for certified organic or reputable brands that follow strict sanitation protocols. Avoid purchasing mushrooms with visible signs of spoilage, such as sliminess or an off odor, as these could indicate bacterial growth.
A comparative analysis reveals that while wild mushrooms face higher inherent risks due to their natural habitat, cultivated mushrooms are not entirely immune to Salmonella. Cross-contamination during processing or packaging can occur if equipment or surfaces are not properly sanitized. For example, a 2019 study found that 5% of cultivated mushroom samples tested positive for Salmonella, primarily due to poor handling practices. This highlights the importance of regulatory oversight and adherence to food safety standards in mushroom cultivation facilities. In contrast, wild mushrooms’ contamination risk is more unpredictable and depends heavily on the forager’s knowledge and practices.
From a practical standpoint, individuals can take proactive steps to ensure mushroom safety. For wild mushrooms, consider using a UV light to inspect them for bacterial presence, as Salmonella can sometimes be invisible to the naked eye. For cultivated mushrooms, store them in the refrigerator at temperatures below 40°F (4°C) to slow bacterial growth. If preparing mushrooms for vulnerable populations, such as young children, pregnant women, or the elderly, always cook them thoroughly to eliminate any potential pathogens. By understanding the unique risks associated with wild and cultivated mushrooms, consumers can make informed choices to enjoy this nutritious food safely.
Freezing Spaghetti Sauce with Mushrooms: Tips for Perfect Preservation
You may want to see also

Food handling practices to prevent salmonella in mushrooms
Mushrooms, while not a common source of salmonella, can become contaminated through contact with contaminated surfaces, water, or handling practices. To prevent salmonella in mushrooms, food handlers must adopt rigorous practices that minimize cross-contamination and ensure proper storage. For instance, mushrooms should be stored at temperatures below 40°F (4°C) to inhibit bacterial growth, and they should never be washed until just before use to prevent moisture-induced spoilage that could foster bacterial proliferation.
Steps to Prevent Salmonella in Mushrooms:
- Source Wisely: Purchase mushrooms from reputable suppliers who adhere to food safety standards. Avoid mushrooms with visible signs of spoilage, such as sliminess or off-odors.
- Separate Equipment: Use dedicated cutting boards and utensils for mushrooms to avoid cross-contamination from raw meats or other high-risk foods.
- Wash Hands and Surfaces: Sanitize hands and work surfaces with a food-safe disinfectant before and after handling mushrooms.
- Cook Thoroughly: While mushrooms are often eaten raw, cooking them to an internal temperature of 165°F (74°C) eliminates any potential pathogens, including salmonella.
Cautions to Consider:
Raw mushrooms intended for consumption without cooking pose a higher risk if not handled properly. Avoid using mushrooms that have been stored in unrefrigerated conditions for more than 2 hours, as this allows bacteria to multiply rapidly. Additionally, be cautious when using wild mushrooms, as improper identification or handling can introduce contaminants beyond salmonella.
Practical Tips for Home Cooks:
Store mushrooms in paper bags rather than plastic to allow air circulation and prevent moisture buildup. If washing is necessary, do so briefly under cold running water and pat dry immediately. For recipes requiring raw mushrooms, such as salads, ensure all ingredients are fresh and handled with clean tools. By integrating these practices, both commercial and home kitchens can significantly reduce the risk of salmonella contamination in mushrooms.
Do Psychedelic Mushrooms Show Up in Standard Drug Tests?
You may want to see also
Explore related products

Symptoms of salmonella poisoning from mushrooms
Mushrooms themselves are not typical carriers of Salmonella, as the bacteria thrive in environments associated with animal products and fecal contamination. However, Salmonella poisoning from mushrooms can occur if they come into contact with contaminated surfaces, water, or handling practices. Understanding the symptoms of Salmonella poisoning in this context is crucial for timely intervention.
Symptoms typically manifest within 6 to 72 hours after ingestion, depending on the dose of bacteria consumed. The most common signs include diarrhea, abdominal cramps, and fever. These symptoms often arise because Salmonella invades the intestinal lining, triggering inflammation and fluid secretion. In cases where mushrooms are the source, the contamination is likely external—from soil, water, or handling—rather than inherent to the mushroom itself.
Severity varies by age and immune status. Young children, the elderly, and immunocompromised individuals are at higher risk for severe symptoms, including dehydration, high fever, and prolonged illness. For example, a child under 5 who consumes contaminated mushrooms might experience rapid dehydration due to frequent diarrhea, requiring immediate rehydration with oral electrolyte solutions. Adults with robust immune systems may recover within 4 to 7 days without treatment, but monitoring for complications like reactive arthritis or bloodstream infections is essential.
Practical tips for prevention and response include thoroughly washing mushrooms before consumption, even if labeled "pre-washed," and avoiding raw mushrooms in high-risk settings like outdoor markets. If symptoms occur, stay hydrated, avoid anti-diarrheal medications (which can prolong bacterial shedding), and seek medical attention if fever exceeds 102°F (39°C) or diarrhea persists beyond 3 days. While mushrooms are rarely the primary culprit, cross-contamination during harvesting or preparation can introduce Salmonella, making vigilance in food safety practices critical.
Can Mushroom Islands Expand? Exploring Their Growth and Spread in Minecraft
You may want to see also

Research on salmonella prevalence in mushroom species
Mushrooms, often celebrated for their nutritional benefits and culinary versatility, are not immune to food safety concerns. Research indicates that certain mushroom species can indeed carry Salmonella, a bacterium notorious for causing foodborne illnesses. Studies have identified contamination primarily in cultivated mushrooms, particularly those grown in environments where cross-contamination with animal feces or unsanitary conditions is possible. Wild mushrooms, while less frequently studied, are not entirely exempt, as they can come into contact with contaminated soil or water sources. Understanding the prevalence of Salmonella in different mushroom species is crucial for both consumers and producers to mitigate health risks.
Analyzing specific studies reveals varying degrees of Salmonella prevalence across mushroom species. For instance, a 2018 study published in the *Journal of Food Protection* found that 5% of tested button mushroom samples carried Salmonella, likely due to contaminated growing substrates. In contrast, shiitake and oyster mushrooms showed lower contamination rates, possibly because of their different cultivation methods and environments. These findings underscore the importance of species-specific research, as not all mushrooms pose the same risk. Producers can use such data to implement targeted safety measures, such as sterilizing growing mediums and ensuring proper hygiene during harvesting and packaging.
From a practical standpoint, consumers can take proactive steps to minimize Salmonella risk when handling mushrooms. Always wash mushrooms thoroughly under running water, even if they are labeled "pre-washed," to remove potential contaminants. Cooking mushrooms to an internal temperature of 165°F (74°C) effectively kills Salmonella and other pathogens. Avoid consuming raw mushrooms, especially for vulnerable populations like young children, pregnant women, and the elderly. Additionally, store mushrooms properly—refrigerate them in paper bags to maintain freshness and prevent bacterial growth.
Comparatively, the risk of Salmonella in mushrooms is lower than in animal-based foods like poultry or eggs, but it is not negligible. Unlike these foods, mushrooms do not inherently harbor Salmonella but can become contaminated through external factors. This distinction highlights the need for preventive measures rather than assuming mushrooms are naturally safe. For example, integrating hazard analysis and critical control points (HACCP) systems in mushroom farming can identify and address contamination risks at various stages, from cultivation to distribution.
In conclusion, while mushrooms are generally safe, research shows that Salmonella prevalence varies by species and cultivation practices. By understanding these nuances, both producers and consumers can adopt evidence-based strategies to reduce risks. Whether through rigorous farming protocols or mindful food handling, ensuring mushroom safety is a shared responsibility that can prevent foodborne illnesses and promote public health.
Shiitake vs. Portobello: Can These Mushrooms Be Swapped in Recipes?
You may want to see also
Frequently asked questions
Yes, mushrooms can carry salmonella if they come into contact with contaminated surfaces, water, or handling practices during cultivation, harvesting, or processing.
Salmonella can contaminate mushrooms through exposure to contaminated soil, water, animal feces, or improper handling during production and packaging.
Yes, raw mushrooms pose a higher risk of carrying salmonella since cooking at appropriate temperatures kills the bacteria, reducing the risk of infection.
Washing mushrooms can reduce the risk of salmonella, but it may not completely eliminate the bacteria. Cooking is the most effective way to ensure safety.
Commercially grown mushrooms are generally less likely to carry salmonella due to controlled growing conditions, but contamination can still occur. Wild mushrooms may have a higher risk due to exposure to natural contaminants.











































